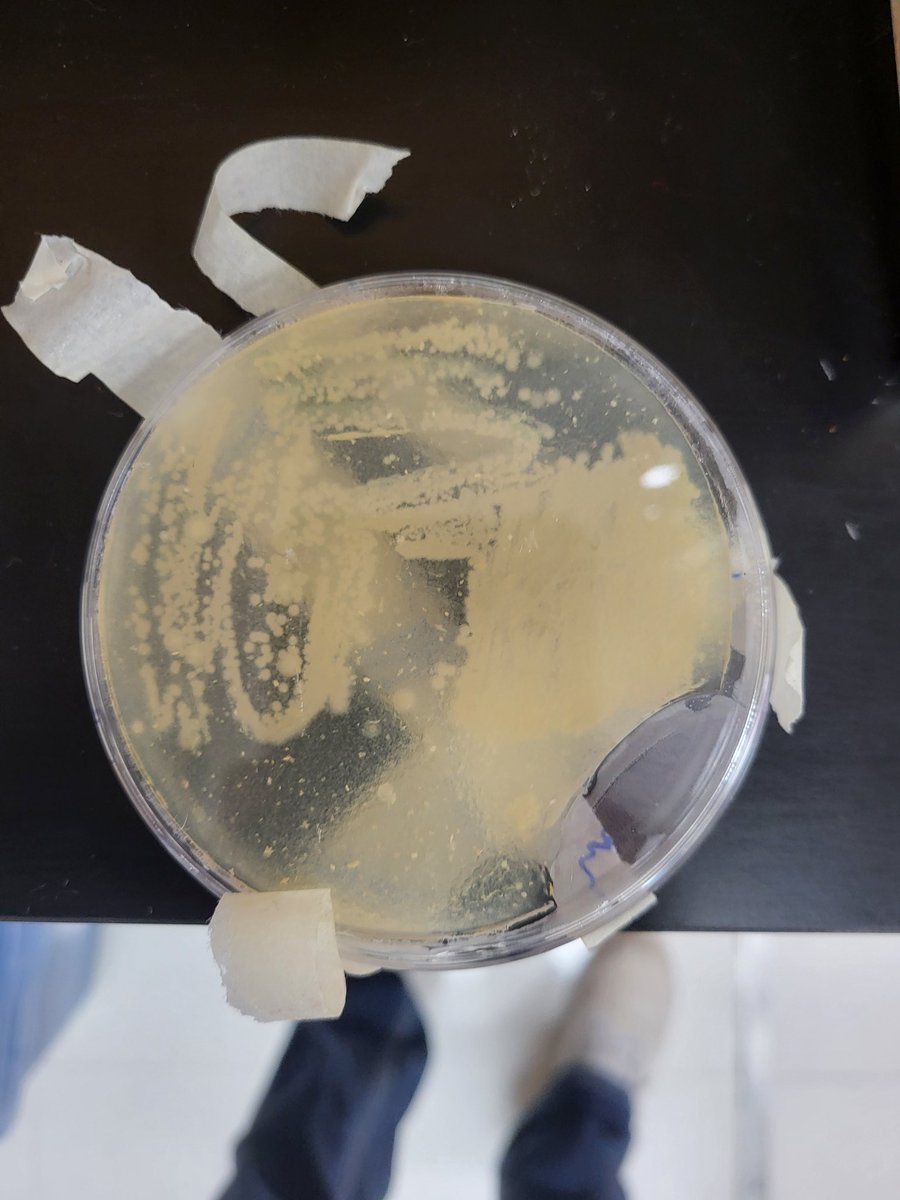
Kaitlyn Zoesch, M. Ed tweet media
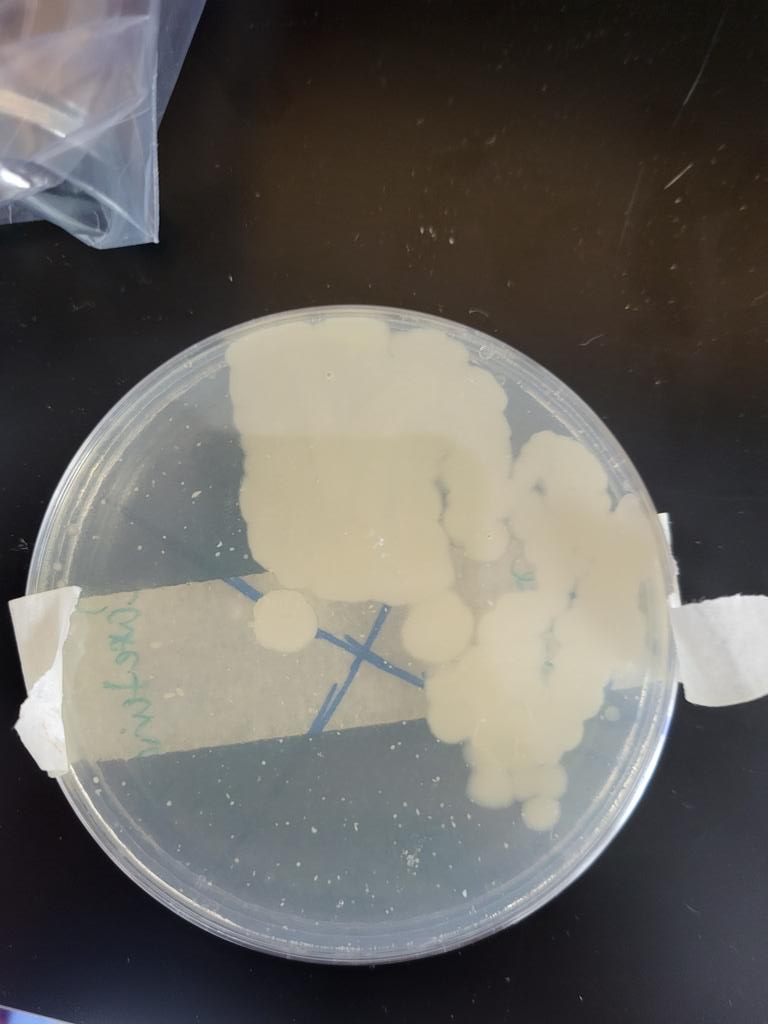
Kaitlyn Zoesch, M. Ed tweet media

This project never fails to make me want to pull my hair out. But seeing kids excited to see their gene put together with their classmates and being able to use this as a reference all year long makes it totally worth it! #RobinsonISD
English
Kaitlyn Zoesch, M. Ed
159 posts

Thank you to Danielle Hughes for sharing her research on teacher retention strategies with our Supt Leadership Academy. Great perspective on dissonance and closing the gap. @Region12Leaders @BaylorSOE

Check out these 8th graders absolutely rocking it in FigJam! 🚀🥳🏆 @MsAshleyShanley is 🐐

















